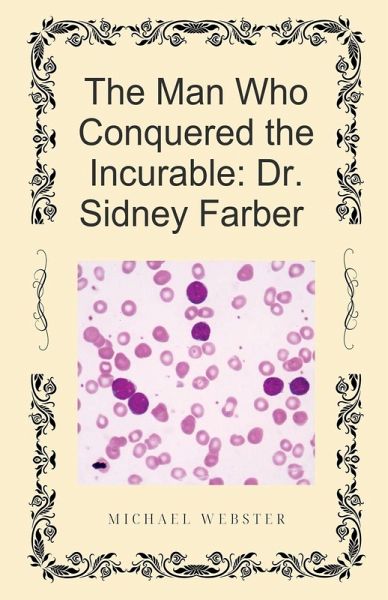
The Man Who Conquered the Incurable

The Man Who Conquered the Incurable
Dr. Sidney Farber
Versandkostenfrei!
Versandfertig in 1-2 Wochen
15,99 €
inkl. MwSt.
PAYBACK Punkte
8 °P sammeln!
In 1948, cancer was a death sentence. For children, leukemia was a swift and brutal certainty. Then came Dr. Sidney Farber. Working from a cramped Boston lab, Farber took an audacious gamble, pioneering the first successful chemotherapy treatment and achieving the world's first temporary remission in a child with cancer. He was the brilliant scientist who became the ultimate political warrior. This is the definitive story of the Father of Modern Oncology: the demanding visionary who didn't just invent a cure, but created the entire infrastructure to fund it. Through the iconic Jimmy Fund and a...
In 1948, cancer was a death sentence. For children, leukemia was a swift and brutal certainty. Then came Dr. Sidney Farber. Working from a cramped Boston lab, Farber took an audacious gamble, pioneering the first successful chemotherapy treatment and achieving the world's first temporary remission in a child with cancer. He was the brilliant scientist who became the ultimate political warrior. This is the definitive story of the Father of Modern Oncology: the demanding visionary who didn't just invent a cure, but created the entire infrastructure to fund it. Through the iconic Jimmy Fund and a relentless lobbying campaign, Farber fundamentally changed American medicine, culminating in the 1971 National Cancer Act-the official launch of the War on Cancer. Discover the complex, singular life of the man who forced a nation to choose hope over despair. Approx.160 pages, 28500 word count